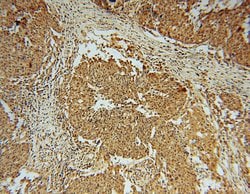
Phospho-RCC1 (Ser12) Rabbit anti-Human, Mouse, Rat, Polyclonal, Proteintech

missing translation for 'onlineSavingsMsg'
Learn More
Learn More
Phospho-RCC1 (Ser12) Rabbit anti-Human, Mouse, Rat, Polyclonal, Proteintech
Rabbit Polyclonal Antibody
Brand: Proteintech 14444-1-AP-20UL
This item is not returnable.
View return policy
Description
This antibody is a rabbit polyclonal antibody raised against human phospho-CHC1 (Ser12) antigen.
TDP43 was first identified as a novel cellular protein that binds to HIV-1 virus TAR DNA sequence motifs and acts a transcriptional repressor to the HIV-1 LTR. Later experiments revealed that TDP43 also regulates the splicing of exon 9 of the cystic fibrosis transmembrane conductance regular (CFTR), most likely through the association with the UG repeats at the 3"e; splice site. A hyperphosphorylated, ubiquitinated, and cleaved form of TDP43 known as pathologic TDP43 is the major disease protein in ubiquitin-positive, tau-, and alpha-synuclein-negative frontotemporal dementia (FLTD-U). TDP43 is not related to TRBP1, and RNA binding protein that binds HIV-1 TAR RNA sequences.Specifications
| Phospho-RCC1 (Ser12) | |
| Polyclonal | |
| Unconjugated | |
| RCC1 | |
| Cell cycle regulatory protein, CHC1, RCC1, RCC1 I | |
| Rabbit | |
| Antigen Affinity Chromatography | |
| RUO | |
| 100088, 1104, 682908 | |
| -20°C | |
| Liquid |
| Immunocytochemistry, Western Blot, Immunofluorescence, Immunohistochemistry (Paraffin) | |
| 0.37 mg/mL | |
| PBS with 50% glycerol and 0.02% sodium azide; pH 7.3 | |
| P18754, Q8VE37 | |
| Rcc1 | |
| Peptide | |
| 20 μL | |
| Primary | |
| Human, Rat, Mouse | |
| Antibody | |
| IgG |
Product Content Correction
Your input is important to us. Please complete this form to provide feedback related to the content on this product.
Product Title
Spot an opportunity for improvement?Share a Content Correction